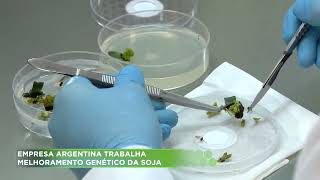

Unknown
0 views2 WordsCopy TextShare
Unknown
Video Transcript:
No transcript available.
Related Videos

31:05
História do Melhoramento Genético de Plant...
Prof. Tomazetti - Genética e Sustentabilidade
5,620 views

24:52
Melhoramento - Hibridação de Plantas.
GENESIS - IFTM
6,151 views

12:08
Como o Brasil produz tanto e tem tanta fome?
Atila Iamarino
251,226 views

8:10
Conheça o melhoramento genético bovino
Conhecendo o Brasil Agro
8,131 views

7:18
Engenharia Genética
Pandêmicos
40,762 views

15:17
7 MORNING HABITS that can SAVE you from a ...
Cardio DF — Cardiologia e saúde cardiovascular em Brasília (DF)
546,730 views

19:55
The Surprising Map of Plants
Domain of Science
1,458,868 views

1:07:40
Plantas Autógamas: Melhoramento Genético p...
Prof. Tomazetti - Genética e Sustentabilidade
12,886 views

16:16
DESENVOLVIMENTO SUSTENTÁVEL...
Tempero Drag
629,987 views

7:45
Tudo sobre melhoramento genético de plantas
AgroPós
950 views

13:53
Domesticação dos animais e plantas | Nerdo...
Nerdologia
416,825 views

7:42
Transformação genética de plantas
Embrapa
36,820 views

33:36
Melhoramento - Sistemas Reprodutivos.
GENESIS - IFTM
3,773 views
7:57
Empresa argentina trabalha melhoramento ge...
Record Brasília
783 views

52:58
Vídeo Aula - Melhoramento Autógamas
Gabriela Kloster
2,029 views

1:03:32
Híbridos | Melhoramento Genético Vegetal
Prof. Tomazetti - Genética e Sustentabilidade
5,884 views

5:10
A IMPORTÂNCIA DO MELHORAMENTO GENÉTICO PAR...
Fernando Espolador
20,127 views

8:36
Melhoramento Genético: como ele é usado na...
TV Meio+
1,370 views

17:36
Clonagem - Biotecnologia - Biologia com o ...
BIOLOGIA com o TUBARÃO
28,821 views

1:21:40
Webinar: Melhoramento Genético do Cacaueir...
Escola Nacional de Gestão Agropecuária
1,670 views